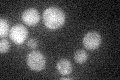

View description
Subunit of an E3 ubiquitin ligase complex involved in resolving replication intermediates or preventing the damage caused by blocked replication forks; regulates Ty1 transposition; involved with Rtt101p in nonfunctional rRNA decay
Localization:
Intensity:
Fold change:
Significance:
-
C’ GFP library in SD
below threshold18.68 -
N' NOP1pr-GFP in SD

cytosol26.662 -
N' TEF2pr-mCherry in SD

missing0 -
N' NATIVEpr-GFP in SD

cytosol20.6947 -
N' TEF2pr-VC and Cyto-VN in SD

#N/A0 -
C’ GFP library in SD+DTT

cytosol16.250.86No -
C’ GFP library in SD+H2O2

cytosol20.51.09No -
C’ GFP library in Starvation Media

cytosol15.250.81No -
C’ GFP library on the background of Pup2-DaMP

below threshold -
C’ GFP library on the background of CCT mutant

below threshold24.24291.29655No
